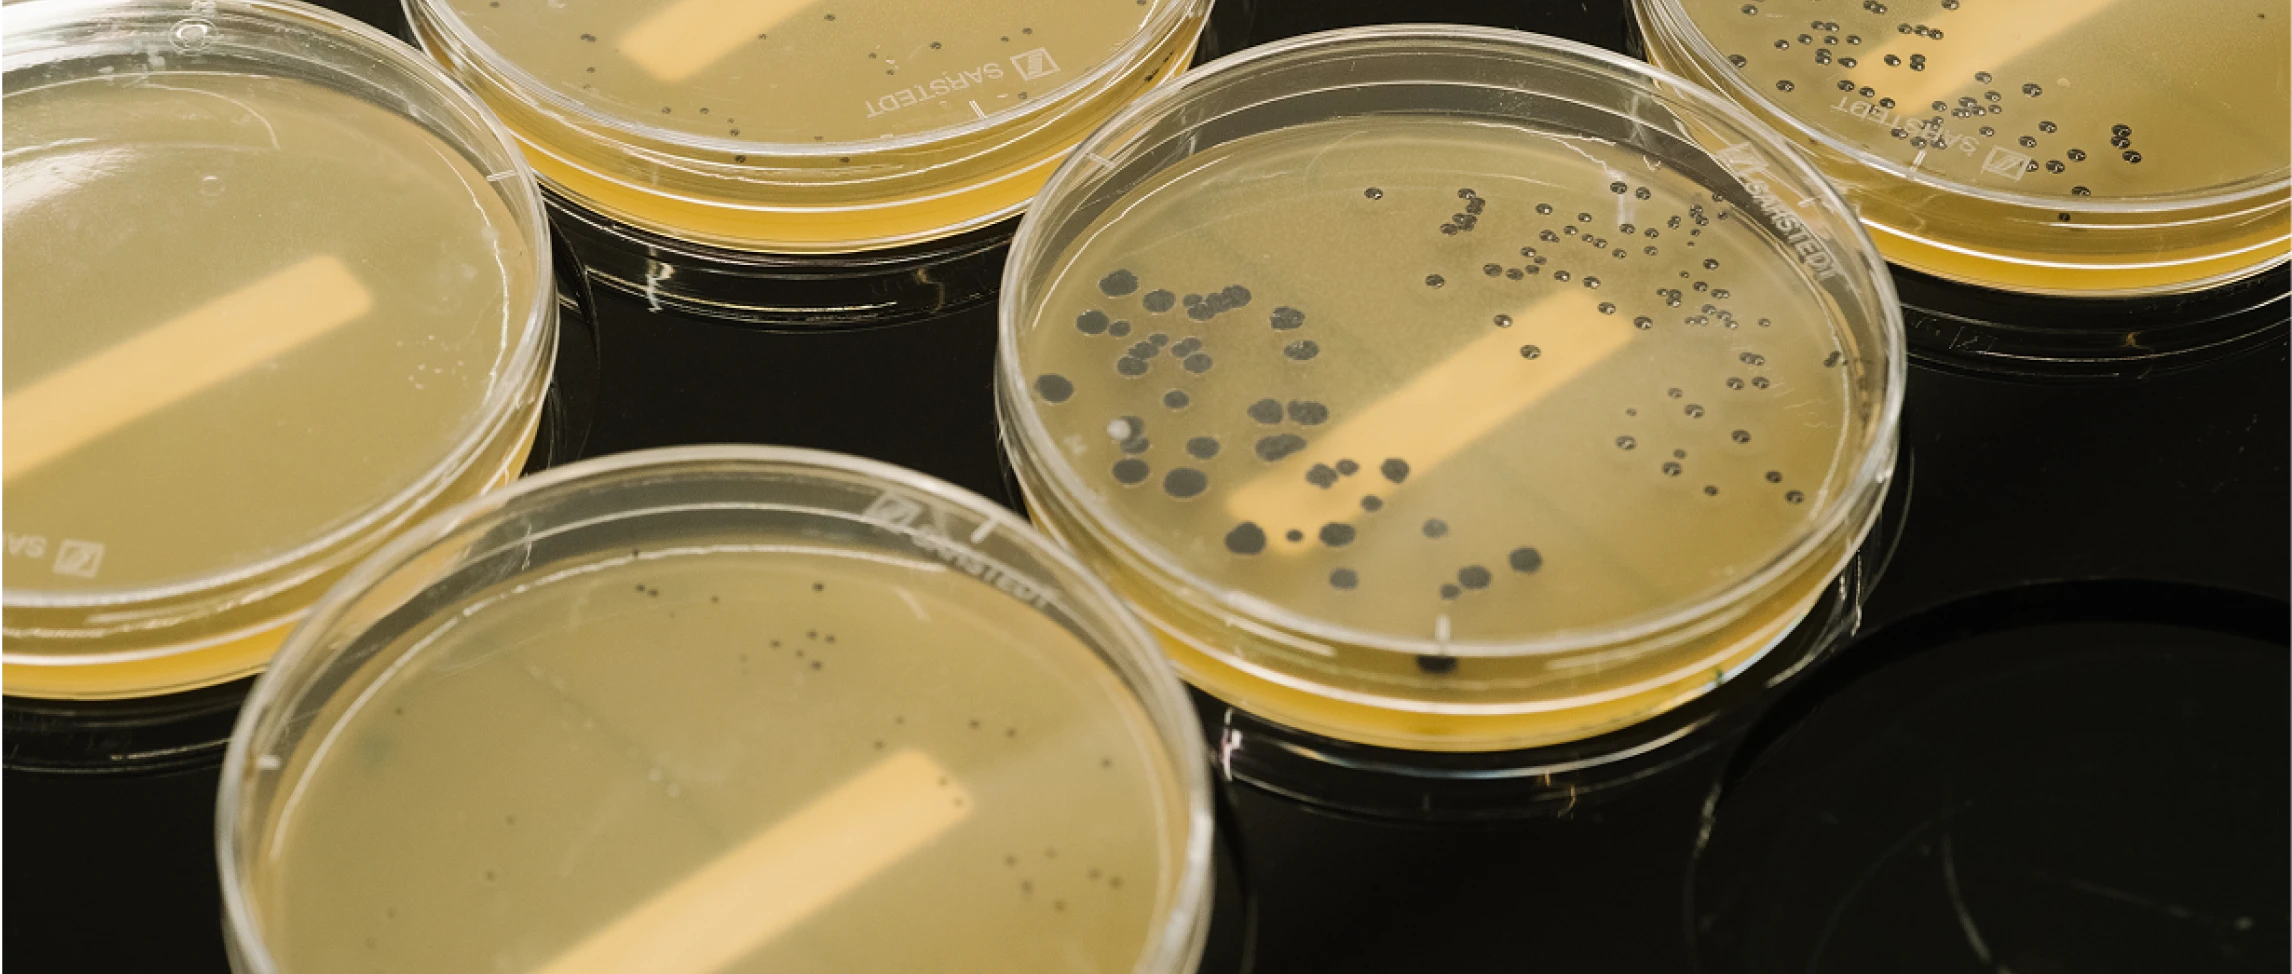
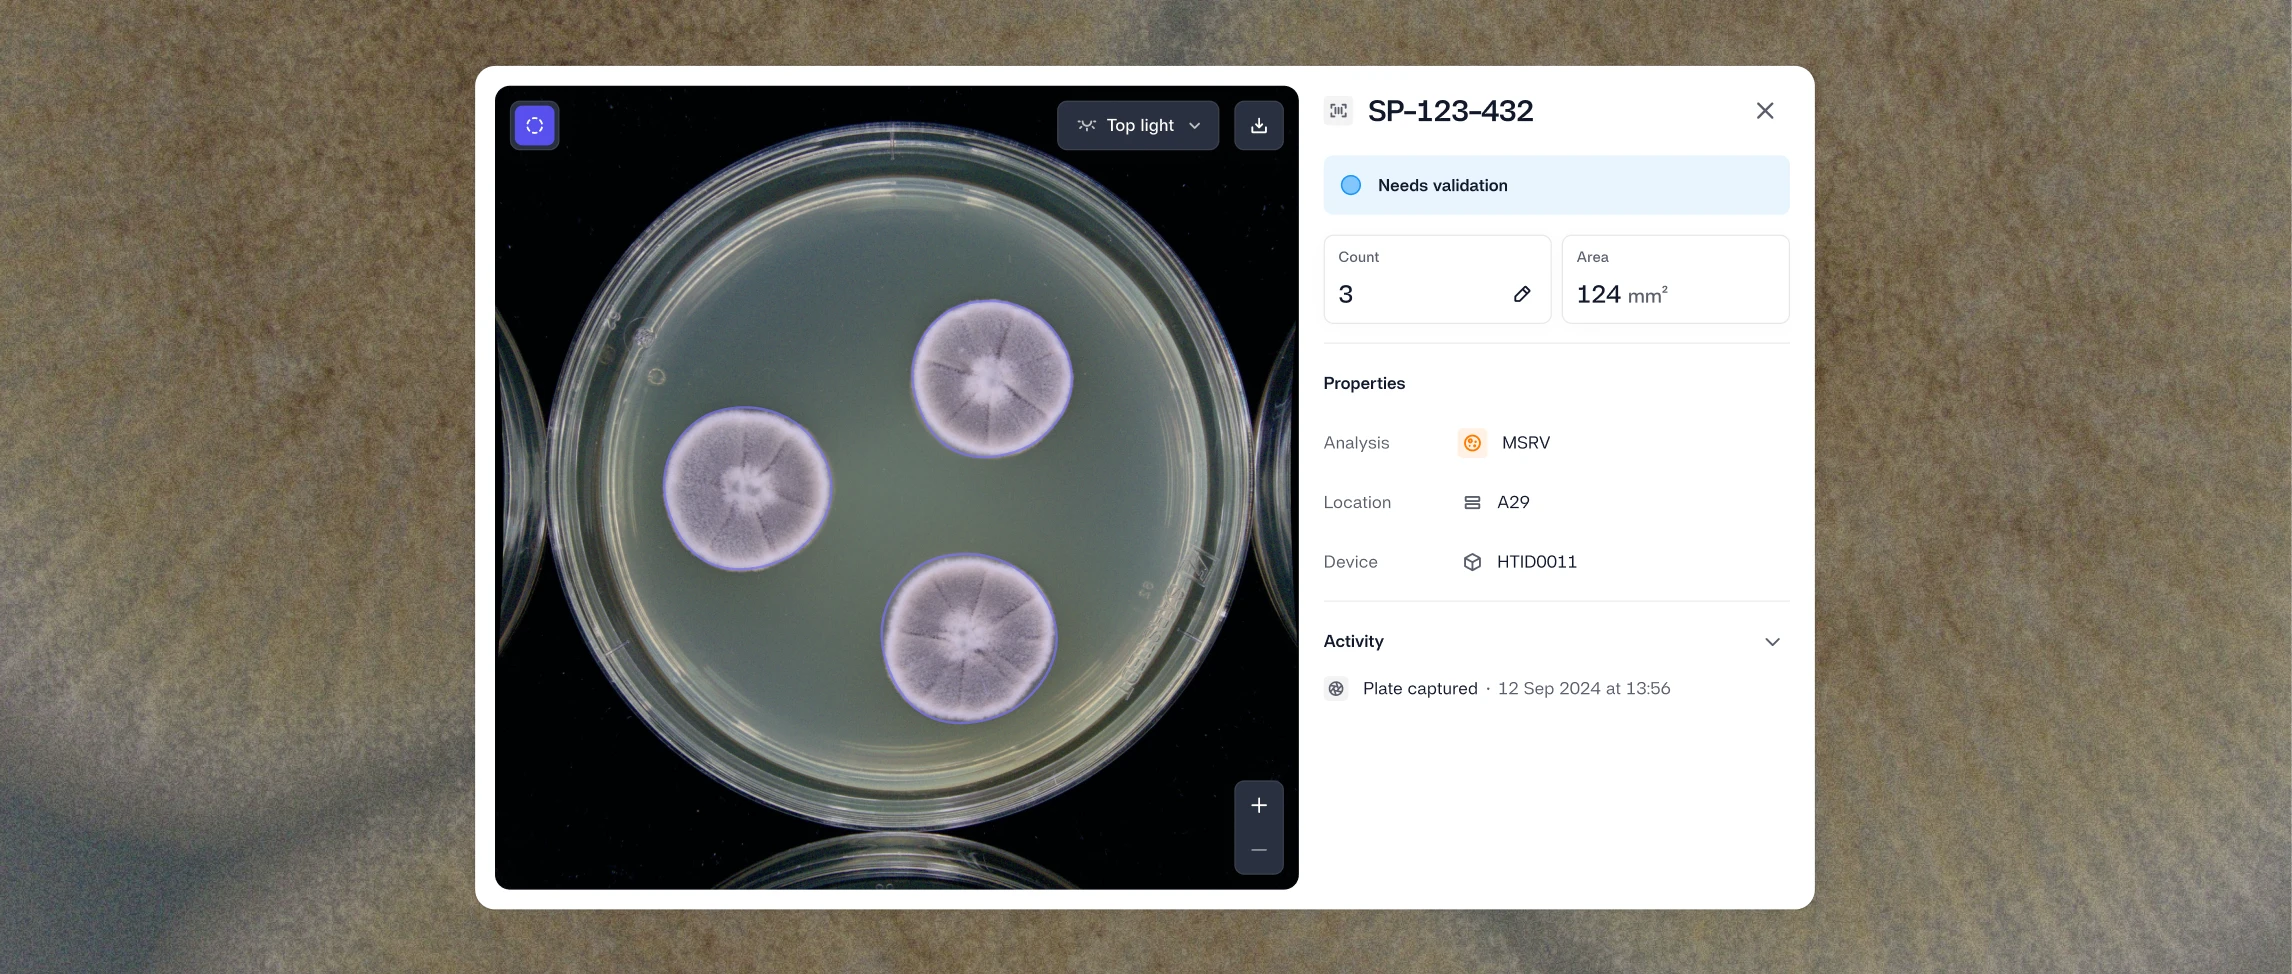
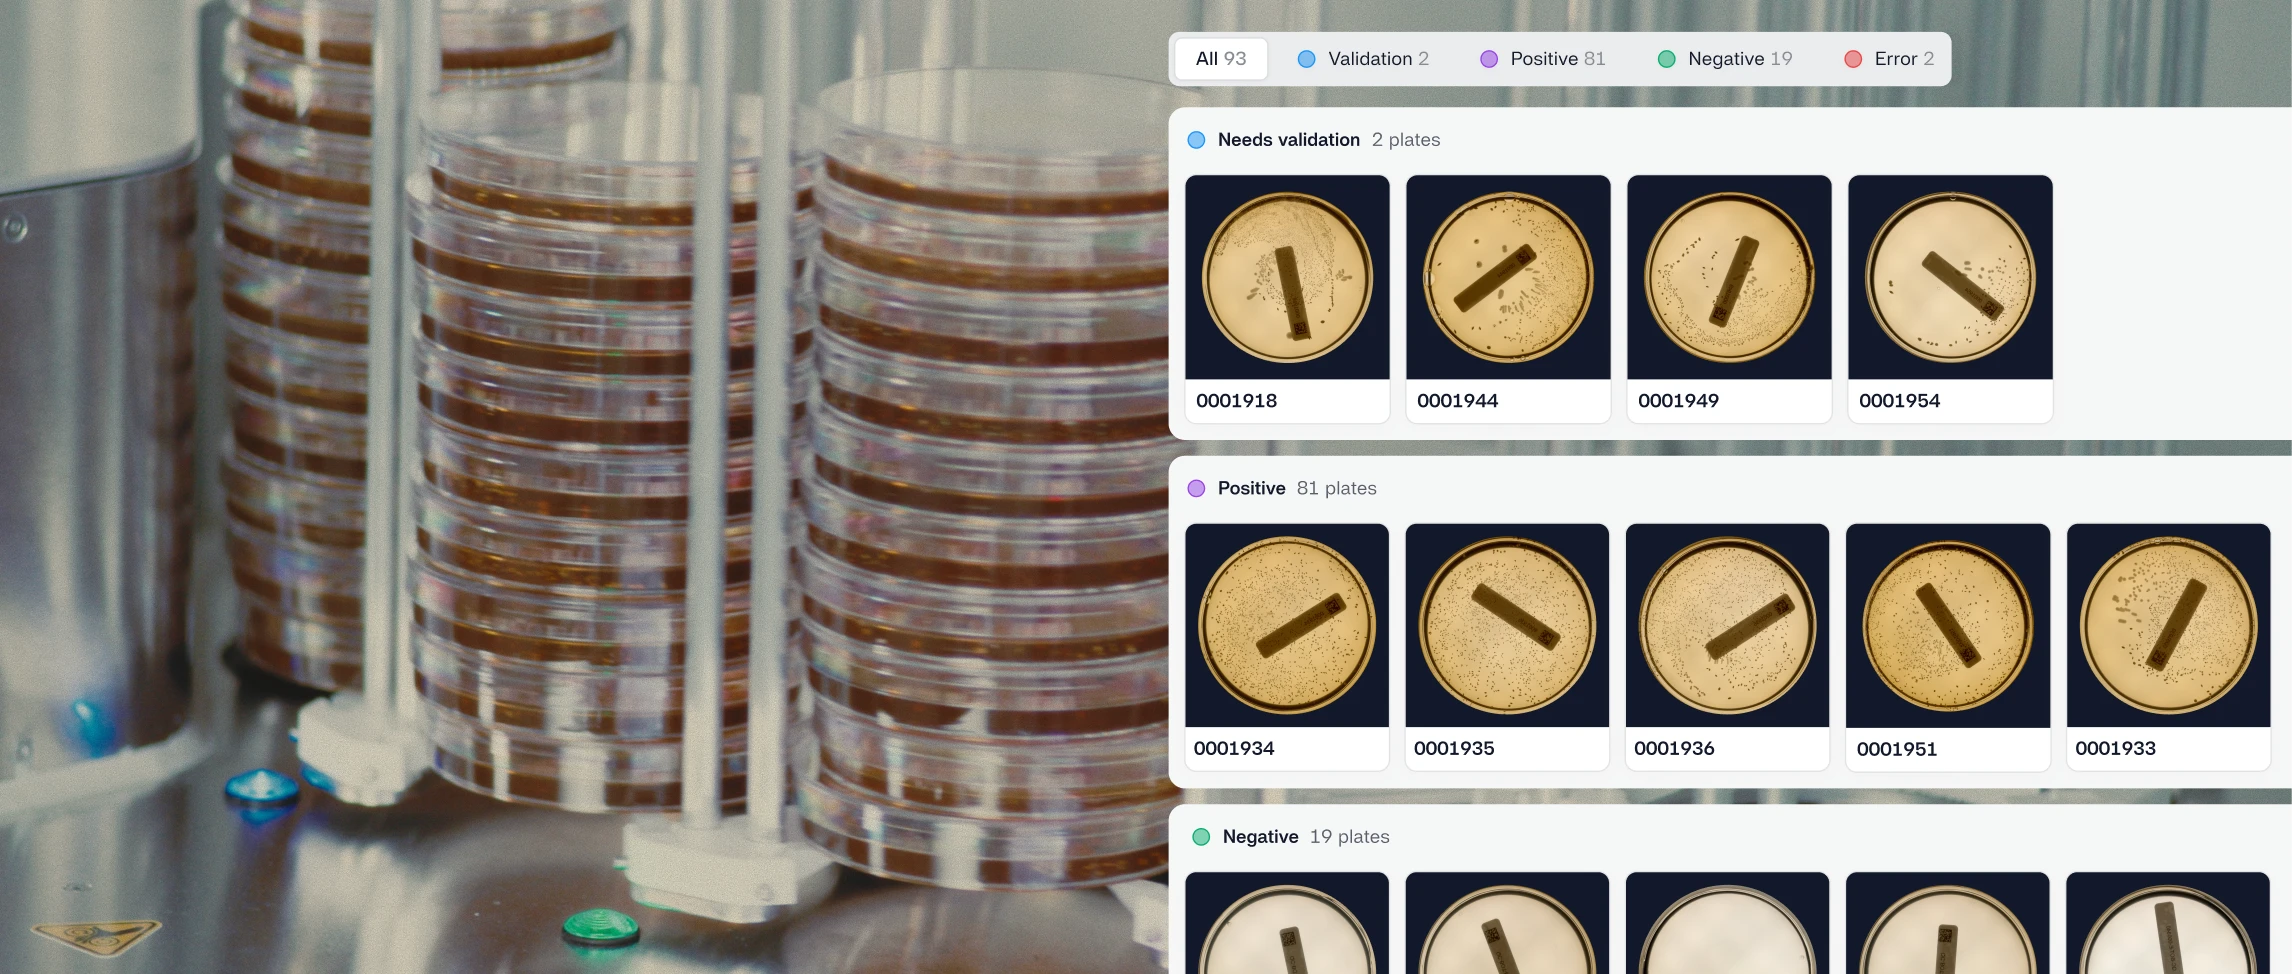
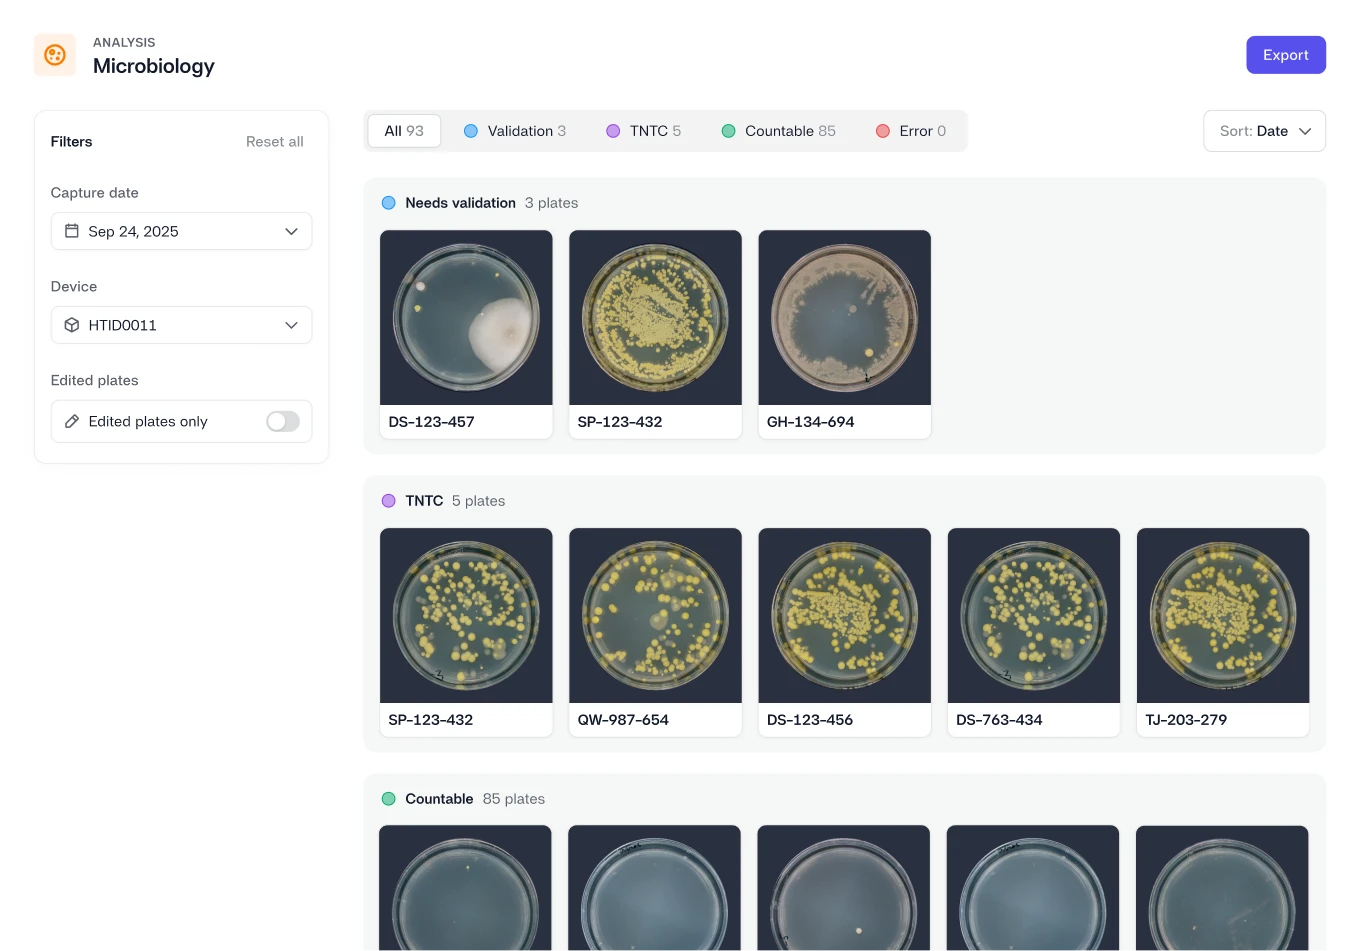
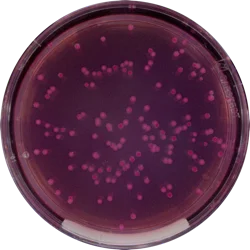
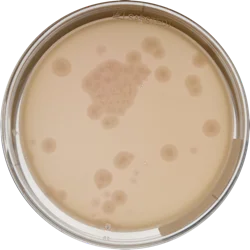
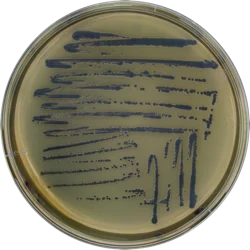
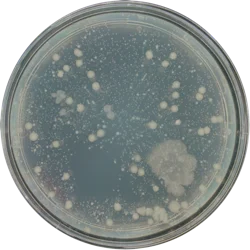
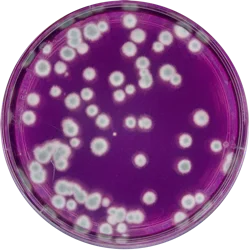
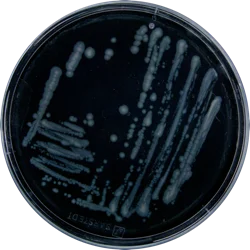
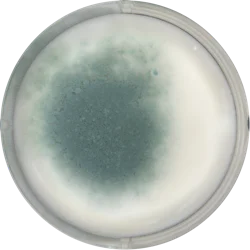
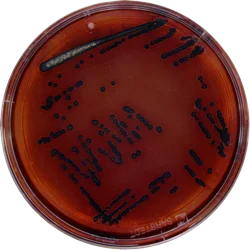
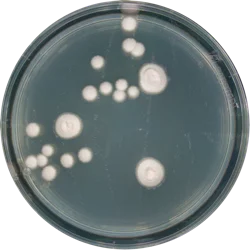
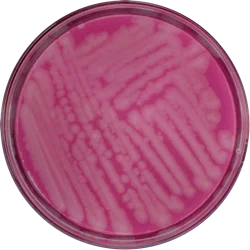
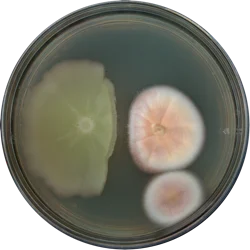
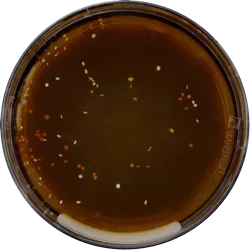
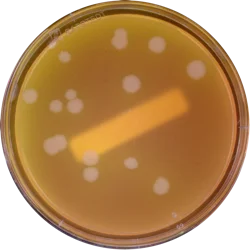
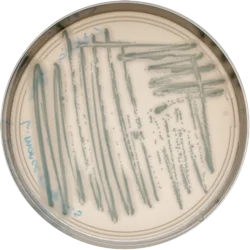
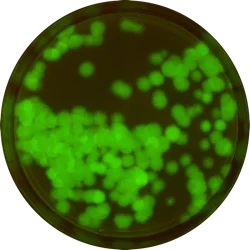

Start every batch of samples with full traceability
Define sample batches upfront, generate plate-level IDs and barcodes, and capture assay conditions before testing begins. This ensures every plate stays linked from preparation through analysis and final results.



Prepare batches faster and with fewer errors
Automatically generate sample IDs, assays, dilutions, and replicates so plates are structured correctly before they reach the bench.
Preserve the full traceability with barcodes
Generate and print plate barcodes, ensuring every sample remains linked to its sample and metadata for interpretation or compliance.
Screen QC samples faster — and more reliably
Reshape automatically captures images and digitizes analysis results for up to 450 plates per hour with the High-throughput Imaging Device. By standardizing QC screening and removing manual interpretation, labs generate consistent, structured results without relying on technician availability.

Get answers faster
Automated imaging and AI analysis process large sample batches continuously, helping labs move from plate to result significantly faster.

Reduce interpretation variability
Standardized imaging and automated analysis remove inconsistencies from manual counting, producing consistent and comparable results across operators and labs.

Strengthen lab resilience
By automating screening and documentation, labs become less dependent on technician availability, training cycles, and workforce fluctuations.



Every result sorted, every outlier surfaced
Reshape automatically sorts results based on predefined thresholds, while highlighting unexpected or borderline plates so teams can quickly focus on what needs review.

Focus attention where it matters
Automatically identify outliers so scientists only review plates that need human judgment.
Keep results organized physically and digitally
Plates are sorted into output carousels while results and images are categorized accordingly in software.
Build a shared global foundation for all QC data
All images, results, and metadata are automatically stored in a secure cloud platform – creating a centralized, searchable record that connects QC results across teams, sites, and time.

Always ready for review
Instantly retrieve past tests, images, and results whenever investigations, audits, or product questions arise.

Enable global QC governance
Share results across labs and sites, making it easy to compare outcomes, monitor trends, and enforce consistent quality standards.

One foundation for global QC governance.
Every batch tracked, every result documented, every site aligned. So when an audit lands, you're ready.





